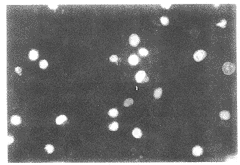

放射线诱导RSV转化神经细胞凋亡的研究
作者:朱广迎 梁克 蔡伟明
单位:朱广迎(221002 徐州,徐州医学院肿瘤研究所);梁克(中国协和医科大学中国医学科学院肿瘤医院);蔡伟明(中国协和医科大学中国医学科学院肿瘤医院)
关键词:
中华放射医学与防护杂志000511 本文首次尝试以凋亡为指标研究RSV(Rous sarcoma virus)转化的大鼠神经细胞R2的放射效应特点,现报告如下。
一、材料和方法
1.细胞培养方法:R2细胞系为中国医学科学院基础所提供。使用DMEM培养基,其中含有10%的小牛血清,每毫升各100单位的青、链霉素及15mg%的谷氨酰胺。于5% CO2(v/v)空气的培养箱中密闭培养,0.25%胰酶消化传代。照射时选择处于指数增殖期的细胞(换液后24 h)。
, http://www.100md.com
2.X射线照射:使用Varian直线加速器产生的6 MeV X射线进行照射,剂量率为250 cGy/min,源皮距为100 cm,射野大小为10 cm×10 cm,照射时于培养瓶上置1.5 cm厚的蜡板(经实测细胞平面百分深度剂量为100%)。
3.细胞的处理及荧光显微镜观察:荧光染料Hoechst 33342\,PI\,EB等分别购自美国Sigma公司,细胞于照射后6、24、48 h处理,用0.25%的胰酶消化数分钟,加入数毫升PBS液,用吹管将细胞打成单细胞悬液,4 000转/分离心10 min,倾去上清,加入PBS液重新离心一次,倾去上清后,加入0.5 ml PBS,再加入30 mg/ml Hoechst 33342 2 μl,于4℃冰箱中作用10 min后吸取一滴于玻片上,用Nikon荧光显微镜下观察。凋亡细胞在荧光镜下的特点为:①细胞膜及核膜完整;②细胞核浓聚缩小,呈单个或多个圆球形,或月牙形聚集于核膜;③细胞体积明显缩小,核浓聚,甚至可见数个这样的小体聚在一起。每个视野连续观察100个细胞,同时计数凋亡细胞数,每个标本随机观察4个视野,求得照射后R2细胞的平均凋亡指数。重复实验3次,结果稳定。
, 百拇医药
4.凝胶电泳:消化离心后的细胞,移入塑料试管中,加入NP40、RnaseA,温箱37℃保温1 h,加入20 mg/ml的蛋白酶K,于37℃保温2 h,移至Eppendorf管中,上样电泳,至2/3胶长时于紫外灯下观察并照相。
二、结果
1.Hoechst 33342染色凋亡R2细胞及凋亡细胞计算:Hoechst 33342染色观察照射后R2细胞的凋亡情况(见图1)。
2.照射后不同时间R2细胞平均凋亡指数(见表1)。
由表1可见随着照射剂量的增加凋亡细胞数也增加,随着观察时间的延长其凋亡指数也上升。
3.不同剂量照射后24 h R2细胞电泳8 Gy,16 Gy照射后可见典型梯形条带。
, http://www.100md.com
图1 16 Gy X射线照射后48 h
荧光显微镜下照片,可见典型凋亡细胞
表1 不同剂量照射后不同时间R2细胞平均凋亡指数 剂量
(Gy)
照后时间
6 h
24 h
48 h
16
4.25±0.50
8.25±0.50
8.75±1.50
, 百拇医药
8
3.75±1.26
5.50±1.29
7.25±0.96
4
2.75±0.96
3.25±0.96
3.25±0.50
0
1.45±0.63
1.26±0.76
1.70±0.55
, http://www.100md.com
三、讨论
近年来随着X刀、γ刀和适形放疗技术的不断改进,许多颅内肿瘤的疗效得到提高,而恶性胶质瘤的疗效仍然较差[1],其重要原因之一是胶质瘤瘤体周围存在已经突变的细胞,因此研究这些细胞的放射生物学特性十分重要,但一般情况下这些细胞难以培养,有必要寻找一种与这些细胞生物学特性类似的细胞来进行模拟研究。R2细胞是突变型RSV转化的大鼠小脑神经细胞系[2],可以满足本实验的需要。
凋亡是一种多基因参与的主动死亡过程,在肿瘤的发生、发展、治疗中都有十分重要的意义,已经成为现代生命科学的研究热点[3,4],凋亡研究分为基因学和形态学两种方法,形态学研究的病理基础是:凋亡细胞胞膜、核膜完整,胞体缩小,胞核浓缩、碎裂,荧光染料结合于DNA双螺旋结构的小沟,受到特定波长的光波激发而发出荧光。基因学研究基于凋亡因素导致细胞内蛋白水解酶激活,继而在核小体之间水解DNA,形成180~200 bp的DNA片段,在末端脱氧核苷酸转移酶作用下把结合生物素的dUTP连接到DNA片段的3’-OH末端,然后通过显色观察凋亡细胞,各种方法各有利弊,为保证研究结果的正确性,本研究同时采用DNA电泳、Hoechst 33342染色荧光显微镜观察两种方法相互验证。我们在研究中发现:①放射线能诱导这种转化细胞发生凋亡;②照射后6 h凋亡分数基本达高峰,24、48 h凋亡分数与6 h相比仅缓慢增加;③照射后R2细胞凋亡率有随剂量增加而增加的趋势;④凋亡过程中有许多细胞碎片,是细胞凋亡形态学重要表现之一;⑤X射线照射引起细胞凋亡不依赖TNF受体超家族中的低亲合力受体P75NGFR,1993年Rabizadeh S等发现这种受体可以诱导多种神经细胞的凋亡[5],本文结果表明放射线能诱导不含P75NGFR的R2细胞凋亡,从一个侧面说明P75NGFR不是放射线诱导凋亡所必须的。
, http://www.100md.com
基金项目:国家自然科学基金和中国医学科学院院校基金资助(39500043)
参考文献
1,Fallai C,Olmi P.Hyperfractionated and accelerated radiation therapy in central nervous system tumors (malignant gliomas,pediatric tumors,and brain metastases).Radiother Oncol,1997,43:235-246.
2,Greenberg ME,Brackenbury R,Edelman GM. Alteration of neural cell adhesion molecule(N-CAM) expression after neuronal cell transformation by Rous sarcoma virus. Proc Natl Acad Sci,1984,81:969-973.
, http://www.100md.com
3,张学军,郭礼和.细胞凋亡失调与疾病关系的研究.中华医学杂志,1998,78:565-566.
4,Rupnow BA,Murtha AD,Alarcon RM,et al. Direct evidence that apoptosis enhances tumor responses to fractionated radiotherapy. Cancer Res,1998,58:1779-1784.
5,Rabizadeh S. Induction of apoptosis by the low-affinity NGF receptor. Science,1993,261:345-348.
(收稿日期:1999-12-10), 百拇医药
单位:朱广迎(221002 徐州,徐州医学院肿瘤研究所);梁克(中国协和医科大学中国医学科学院肿瘤医院);蔡伟明(中国协和医科大学中国医学科学院肿瘤医院)
关键词:
中华放射医学与防护杂志000511 本文首次尝试以凋亡为指标研究RSV(Rous sarcoma virus)转化的大鼠神经细胞R2的放射效应特点,现报告如下。
一、材料和方法
1.细胞培养方法:R2细胞系为中国医学科学院基础所提供。使用DMEM培养基,其中含有10%的小牛血清,每毫升各100单位的青、链霉素及15mg%的谷氨酰胺。于5% CO2(v/v)空气的培养箱中密闭培养,0.25%胰酶消化传代。照射时选择处于指数增殖期的细胞(换液后24 h)。
, http://www.100md.com
2.X射线照射:使用Varian直线加速器产生的6 MeV X射线进行照射,剂量率为250 cGy/min,源皮距为100 cm,射野大小为10 cm×10 cm,照射时于培养瓶上置1.5 cm厚的蜡板(经实测细胞平面百分深度剂量为100%)。
3.细胞的处理及荧光显微镜观察:荧光染料Hoechst 33342\,PI\,EB等分别购自美国Sigma公司,细胞于照射后6、24、48 h处理,用0.25%的胰酶消化数分钟,加入数毫升PBS液,用吹管将细胞打成单细胞悬液,4 000转/分离心10 min,倾去上清,加入PBS液重新离心一次,倾去上清后,加入0.5 ml PBS,再加入30 mg/ml Hoechst 33342 2 μl,于4℃冰箱中作用10 min后吸取一滴于玻片上,用Nikon荧光显微镜下观察。凋亡细胞在荧光镜下的特点为:①细胞膜及核膜完整;②细胞核浓聚缩小,呈单个或多个圆球形,或月牙形聚集于核膜;③细胞体积明显缩小,核浓聚,甚至可见数个这样的小体聚在一起。每个视野连续观察100个细胞,同时计数凋亡细胞数,每个标本随机观察4个视野,求得照射后R2细胞的平均凋亡指数。重复实验3次,结果稳定。
, 百拇医药
4.凝胶电泳:消化离心后的细胞,移入塑料试管中,加入NP40、RnaseA,温箱37℃保温1 h,加入20 mg/ml的蛋白酶K,于37℃保温2 h,移至Eppendorf管中,上样电泳,至2/3胶长时于紫外灯下观察并照相。
二、结果
1.Hoechst 33342染色凋亡R2细胞及凋亡细胞计算:Hoechst 33342染色观察照射后R2细胞的凋亡情况(见图1)。
2.照射后不同时间R2细胞平均凋亡指数(见表1)。
由表1可见随着照射剂量的增加凋亡细胞数也增加,随着观察时间的延长其凋亡指数也上升。
3.不同剂量照射后24 h R2细胞电泳8 Gy,16 Gy照射后可见典型梯形条带。
, http://www.100md.com
图1 16 Gy X射线照射后48 h
荧光显微镜下照片,可见典型凋亡细胞
表1 不同剂量照射后不同时间R2细胞平均凋亡指数 剂量
(Gy)
照后时间
6 h
24 h
48 h
16
4.25±0.50
8.25±0.50
8.75±1.50
, 百拇医药
8
3.75±1.26
5.50±1.29
7.25±0.96
4
2.75±0.96
3.25±0.96
3.25±0.50
0
1.45±0.63
1.26±0.76
1.70±0.55
, http://www.100md.com
三、讨论
近年来随着X刀、γ刀和适形放疗技术的不断改进,许多颅内肿瘤的疗效得到提高,而恶性胶质瘤的疗效仍然较差[1],其重要原因之一是胶质瘤瘤体周围存在已经突变的细胞,因此研究这些细胞的放射生物学特性十分重要,但一般情况下这些细胞难以培养,有必要寻找一种与这些细胞生物学特性类似的细胞来进行模拟研究。R2细胞是突变型RSV转化的大鼠小脑神经细胞系[2],可以满足本实验的需要。
凋亡是一种多基因参与的主动死亡过程,在肿瘤的发生、发展、治疗中都有十分重要的意义,已经成为现代生命科学的研究热点[3,4],凋亡研究分为基因学和形态学两种方法,形态学研究的病理基础是:凋亡细胞胞膜、核膜完整,胞体缩小,胞核浓缩、碎裂,荧光染料结合于DNA双螺旋结构的小沟,受到特定波长的光波激发而发出荧光。基因学研究基于凋亡因素导致细胞内蛋白水解酶激活,继而在核小体之间水解DNA,形成180~200 bp的DNA片段,在末端脱氧核苷酸转移酶作用下把结合生物素的dUTP连接到DNA片段的3’-OH末端,然后通过显色观察凋亡细胞,各种方法各有利弊,为保证研究结果的正确性,本研究同时采用DNA电泳、Hoechst 33342染色荧光显微镜观察两种方法相互验证。我们在研究中发现:①放射线能诱导这种转化细胞发生凋亡;②照射后6 h凋亡分数基本达高峰,24、48 h凋亡分数与6 h相比仅缓慢增加;③照射后R2细胞凋亡率有随剂量增加而增加的趋势;④凋亡过程中有许多细胞碎片,是细胞凋亡形态学重要表现之一;⑤X射线照射引起细胞凋亡不依赖TNF受体超家族中的低亲合力受体P75NGFR,1993年Rabizadeh S等发现这种受体可以诱导多种神经细胞的凋亡[5],本文结果表明放射线能诱导不含P75NGFR的R2细胞凋亡,从一个侧面说明P75NGFR不是放射线诱导凋亡所必须的。
, http://www.100md.com
基金项目:国家自然科学基金和中国医学科学院院校基金资助(39500043)
参考文献
1,Fallai C,Olmi P.Hyperfractionated and accelerated radiation therapy in central nervous system tumors (malignant gliomas,pediatric tumors,and brain metastases).Radiother Oncol,1997,43:235-246.
2,Greenberg ME,Brackenbury R,Edelman GM. Alteration of neural cell adhesion molecule(N-CAM) expression after neuronal cell transformation by Rous sarcoma virus. Proc Natl Acad Sci,1984,81:969-973.
, http://www.100md.com
3,张学军,郭礼和.细胞凋亡失调与疾病关系的研究.中华医学杂志,1998,78:565-566.
4,Rupnow BA,Murtha AD,Alarcon RM,et al. Direct evidence that apoptosis enhances tumor responses to fractionated radiotherapy. Cancer Res,1998,58:1779-1784.
5,Rabizadeh S. Induction of apoptosis by the low-affinity NGF receptor. Science,1993,261:345-348.
(收稿日期:1999-12-10), 百拇医药